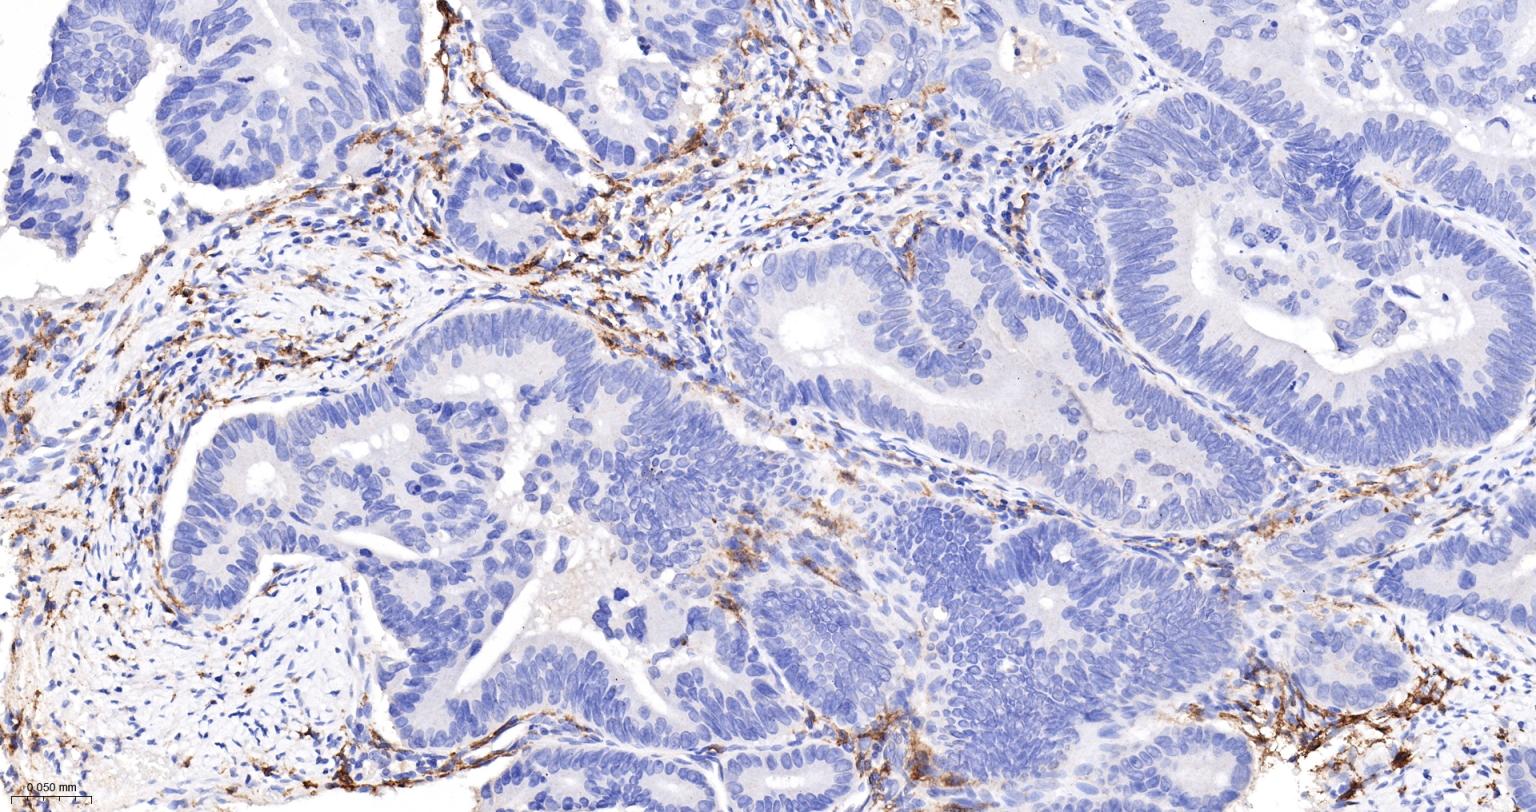
组织相容性复合体2重组兔单抗
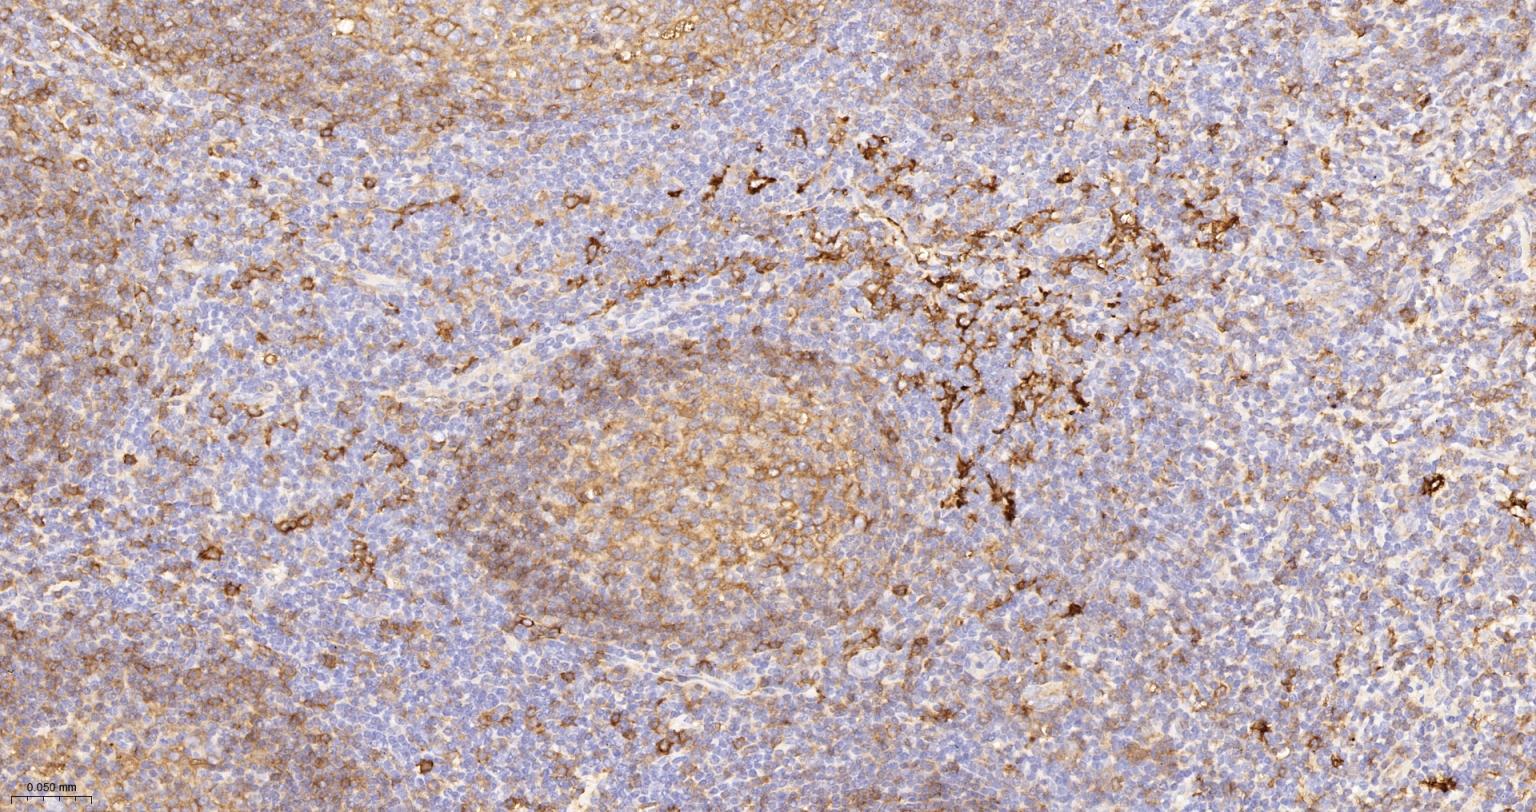
组织相容性复合体2重组兔单抗

HLA-DPB1 Recombinant Rabbit mAb (一抗) - WB,IHC-P,IHC-F,IF,ICC/IF | Bioss

概述
HLA-DMB belongs to the HLA class II beta chain paralogues. This class II molecule is a heterodimer consisting of an alpha (DMA) and a beta (DMB) chain, both anchored in the membrane. It is located in intracellular vesicles. DM plays a central role in the peptide loading of MHC class II molecules by helping to release the CLIP (class II-associated invariant chain peptide) molecule from the peptide binding site. Class II molecules are expressed in antigen presenting cells (APC: B lymphocytes, dendritic cells, macrophages). The beta chain is approximately 26-28 kDa and its gene contains 6 exons. Exon one encodes the leader peptide, exons 2 and 3 encode the two extracellular domains, exon 4 encodes the transmembrane domain and exon 5 encodes the cytoplasmic tail. [provided by RefSeq, Jul 2008]

产品应用
| 应用 | 已检合格种属 | 预测种属 | 推荐稀释比例 |
|---|---|---|---|
| WB | Human | 1:2000-20000 | |
| IHC-P | Human | 1:200-1000 | |
| IHC-F | Human | 1:200-1000 | |
| IF | Human | 1:200-1000 | |
| ICC/IF | Human | 1:100-500 |
交叉反应
交叉反应: Human
相关产品
暂无相关产品
靶标
Contains 1 Ig-like C1-type (immunoglobulin-like) domain.